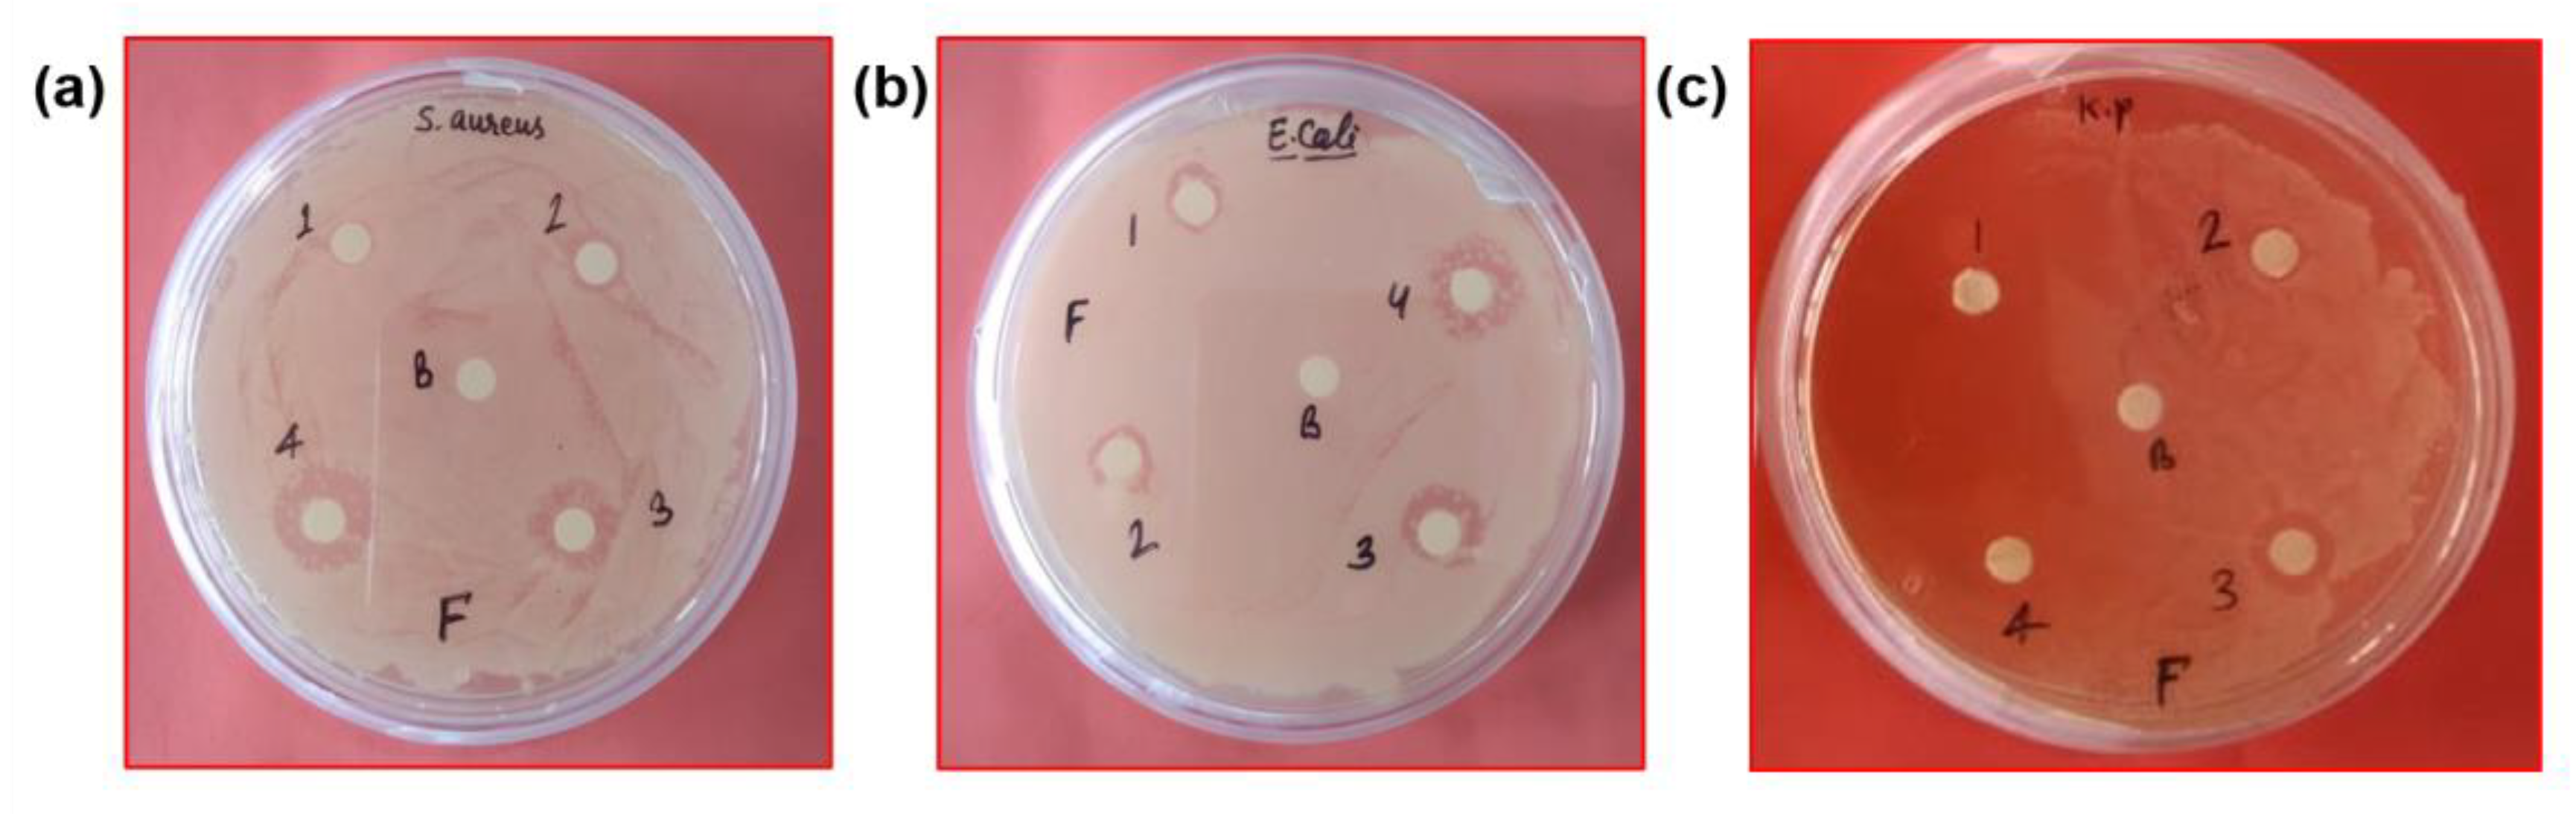
Pharmaceutics 15 01726 g007 Pharmaceutics 15 01726 g007

A Facile Synthesis of Flower-like Iron Oxide Nanoparticles and Its Efficacy Measurements for Antibacterial, Cytotoxicity and Antioxidant Activity
Abstract
1. Introduction
2. Materials and Methods
2.1. Chemicals and Reagents
2.2. Synthesis of Fe2O3 Nanoparticles
2.3. Instrumentation
2.4. Evaluation of the Cytotoxic Activity of Fe2O3 Nanoparticles
2.4.1. Cell Culture
2.4.2. MTT Assay
2.5. Antibacterial Activity of Fe2O3 Nanoparticles
2.6. Antioxidant Activity of Fe2O3 Nanoparticles
2.7. Statistical Analysis
3. Results and Discussion
3.1. Physicochemical Characterization of Fe2O3 Nanoparticles
3.2. Morphology and Elemental Mapping of Fe2O3 Nanoparticles
3.3. In Vitro Cytotoxicity Assay of Fe2O3 Nanoparticles
3.4. In Vitro Antibacterial Assessment of Fe2O3 Nanoparticles
3.5. Antioxidant Efficiency of Fe2O3 Nanoparticles: A Possible Mechanism of Action for Antibacterial and Cytotoxic Activity
4. Conclusions
Author Contributions
Funding
Institutional Review Board Statement
Informed Consent Statement
Data Availability Statement
Acknowledgments
Conflicts of Interest
References
- Khan, I.; Saeed, K.; Khan, I. Nanoparticles: Properties, applications and toxicities. Arab. J. Chem. 2019, 12, 908–931. [Google Scholar] [CrossRef]
- Salata, O.V. Applications of nanoparticles in biology and medicine. J. Nanobiotechnol. 2004, 2, 3. [Google Scholar] [CrossRef] [PubMed]
- Soni, A.; Bhandari, M.P.; Tripathi, G.K.; Bundela, P.; Khiriya, P.K.; Khare, P.S.; Pérez de la Lastra, J.M. Nano-biotechnology in tumour and cancerous disease: A perspective review. J. Cell. Mol. Med. 2023, 27, 737–762. [Google Scholar] [CrossRef] [PubMed]
- Dutt, Y.; Pandey, R.P.; Dutt, M.; Gupta, A.; Vibhuti, A.; Vidic, J.; Priyadarshini, A. Therapeutic applications of nanobiotechnology. J. Nanobiotech. 2023, 21, 148. [Google Scholar] [CrossRef] [PubMed]
- Ullah, Z.; Gul, F.; Iqbal, J.; Abbasi, B.A.; Kanwal, S.; Chalgham, W.; El-Sheikh, M.A.; Diltemiz, S.A.; Mahmood, T. Biogenic Synthesis of Multifunctional Silver Oxide Nanoparticles (Ag2ONPs) Using Parieteria alsinaefolia Delile Aqueous Extract and Assessment of Their Diverse Biological Applications. Microorganisms 2023, 11, 1069. [Google Scholar] [CrossRef]
- Malik, S.B.; Gul, A.; Saggu, J.I.; Abbasi, B.A.; Azad, B.; Iqbal, J.; Kazi, M.; Chalgham, W.; Firoozabadi, S.A.M. Fabrication and Characterization of Ag-Graphene Nanocomposites and Investigation of Their Cytotoxic, Antifungal and Photocatalytic Potential. Molecules 2023, 28, 4139. [Google Scholar] [CrossRef]
- Haris, M.; Fatima, N.; Iqbal, J.; Chalgham, W.; Mumtaz, A.S.; El-Sheikh, M.A.; Tavafoghi, M. Oscillatoria limnetica Mediated Green Synthesis of Iron Oxide (Fe2O3) Nanoparticles and Their Diverse In Vitro Bioactivities. Molecules 2023, 28, 2091. [Google Scholar] [CrossRef]
- Zhang, Q.; Yang, X.; Guan, J. Applications of magnetic nanomaterials in heterogeneous catalysis. ACS Appl. Nano Mater. 2019, 2, 4681–4697. [Google Scholar] [CrossRef]
- Nandwana, V.; De, M.; Chu, S.; Jaiswal, M.; Rotz, M.; Meade, T.J.; Dravid, V.P. Theranostic magnetic nanostructures (MNS) for cancer. Cancer Treat. Res. 2015, 166, 51–83. [Google Scholar] [CrossRef]
- Zhao, S.; Yu, X.; Qian, Y.; Chen, W.; Shen, J. Multifunctional magnetic iron oxide nanoparticles: An advanced platform for cancer theranostics. Theranostics 2020, 10, 6278. Available online: https://www.thno.org/v10p6278.html (accessed on 15 May 2020). [CrossRef]
- Cui, H.; Liu, Y.; Ren, W. Structure switch between α-Fe2O3, γ-Fe2O3 and Fe3O4 during the large scale and low temperature sol–gel synthesis of nearly monodispersed iron oxide nanoparticles. Adv. Powder Technol. 2013, 24, 93–97. [Google Scholar] [CrossRef]
- Wu, W.; Wu, Z.; Yu, T.; Jiang, C.; Kim, W.S. Recent progress on magnetic iron oxide nanoparticles: Synthesis, surface functional strategies and biomedical applications. Sci. Technol. Adv. Mater. 2015, 16, 023501. [Google Scholar] [CrossRef] [PubMed]
- Ajinkya, N.; Yu, X.; Kaithal, P.; Luo, H.; Somani, P.; Ramakrishna, S. Magnetic Iron Oxide Nanoparticle (IONP) Synthesis to Applications: Present and Future. Materials 2020, 13, 4644. [Google Scholar] [CrossRef] [PubMed]
- Tadic, M.; Panjan, M.; Damnjanovic, V.; Milosevic, I. Magnetic properties of hematite (α-Fe2O3) nanoparticles prepared by hydrothermal synthesis method. Appl. Surf. Sci. 2014, 320, 183–187. [Google Scholar] [CrossRef]
- Vecchio, C.L.; Trocino, S.; Zignani, S.C.; Baglio, V.; Carbone, A.; Garcia, M.I.D.; Aricò, A.S. Enhanced photoelectrochemical water splitting at hematite photoanodes by effect of a NiFe-oxide co-catalyst. Catalysts 2020, 10, 525. [Google Scholar] [CrossRef]
- Arias, L.S.; Pessan, J.P.; Vieira, A.P.M.; Lima, T.M.T.D.; Delbem, A.C.B.; Monteiro, D.R. Iron oxide nanoparticles for biomedical applications: A perspective on synthesis, drugs, antimicrobial activity, and toxicity. Antibiotics 2018, 7, 46. [Google Scholar] [CrossRef]
- Besenhard, M.O.; LaGrow, A.P.; Hodzic, A.; Kriechbaum, M.; Panariello, L.; Bais, G.; Gavriilidis, A. Co-precipitation synthesis of stable iron oxide nanoparticles with NaOH: New insights and continuous production via flow chemistry. Chem. Eng. Process. 2020, 399, 125740. [Google Scholar] [CrossRef]
- Arsalani, S.; Oliveira, J.; Guidelli, E.J.; Araujo, J.F.; Wiekhorst, F.; Baffa, O. Synthesis of radioluminescent iron oxide nanoparticles functionalized by anthracene for biomedical applications. Colloids Surf. A Physicochem. Eng. Asp. 2020, 602, 125105. [Google Scholar] [CrossRef]
- Saqib, S.; Munis, M.F.H.; Zaman, W.; Ullah, F.; Shah, S.N.; Ayaz, A.; Bahadur, S. Synthesis, characterization and use of iron oxide nano particles for antibacterial activity. Microsc. Res. Tech. 2019, 82, 415–420. [Google Scholar] [CrossRef]
- Farahmandjou, M.; Soflaee, F. Synthesis and characterization of α-Fe2O3 nanoparticles by simple co-precipitation method. Phys. Chem. Res. 2015, 3, 191–196. [Google Scholar] [CrossRef]
- Ali, A.; Hira Zafar, M.Z.; ul Haq, I.; Phull, A.R.; Ali, J.S.; Hussain, A. Synthesis, characterization, applications, and challenges of iron oxide nanoparticles. Nanotech. Sci. Appl. 2016, 9, 49. [Google Scholar] [CrossRef] [PubMed]
- Alangari, A.; Alqahtani, M.S.; Mateen, A.; Kalam, M.A.; Alshememry, A.; Ali, R.; Syed, R. Iron oxide nanoparticles: Preparation, characterization, and assessment of antimicrobial and anticancer activity. Adsorp. Sci. Technol. 2022, 2022, 1562051. [Google Scholar] [CrossRef]
- Pradhan, D.; Pradhan, S.; Behera, B.; Samantaray, A. Screening of Cytotoxic Activity of Hematite (a-Fe2O3) Nanoparticles from Butea monosperma on MCF-7 Cells. Pharmacogn. Res. 2021, 13, 260–266. [Google Scholar]
- Ali, H.R.; Nassar, H.N.; El-Gendy, N.S. Green synthesis of α-Fe2O3 using Citrus reticulum peels extract and water decontamination from different organic pollutants. Energy Sources Part A Recovery Util. 2017, 39, 1425–1434. [Google Scholar] [CrossRef]
- Mosdam, T. Rapid colorimetric assay for cellular growth and survival: Application to proliferation and cytotoxic assay. J. Immunol. Methods 1983, 65, 55–63. [Google Scholar] [CrossRef]
- Kasithevar, M.; Saravanan, M.; Prakash, P.; Kumar, H.; Ovais, M.; Barabadi, H.; Shinwari, Z.K. Green synthesis of silver nanoparticles using Alysicarpus monilifer leaf extract and its antibacterial activity against MRSA and CoNS isolates in HIV patients. J. Interdiscip. Nanomed. 2017, 2, 131–141. [Google Scholar] [CrossRef]
- Kurechi, T.; Kikugawa, K.; Kato, T. Studies on the antioxidants. XIII. Hydrogen donating capability of antioxidants to 2, 2-diphenyl-1-picrylhydrazyl. Chem. Pharm. Bull. 1980, 28, 2089–2093. [Google Scholar] [CrossRef]
- Pourmadadi, M.; Rahmani, E.; Shamsabadipour, A.; Mahtabian, S.; Ahmadi, M.; Rahdar, A.; Díez-Pascual, A.M. Role of Iron Oxide (Fe2O3) Nanocomposites in Advanced Biomedical Applications: A State-of-the-Art Review. Nanomaterials 2022, 12, 3873. [Google Scholar] [CrossRef]
- Xu, Y.Y.; Zhao, D.; Zhang, X.J.; Jin, W.T.; Kashkarov, P.; Zhang, H. Synthesis and characterization of single-crystalline α-Fe2O3 nanoleaves. Phys. E Low. Dimens. Syst. Nanostruct. 2009, 41, 806–811. [Google Scholar] [CrossRef]
- Zhang, G.Y.; Xu, Y.Y.; Gao, D.Z.; Sun, Y.Q. α-Fe2O3 nanoplates: PEG-600 assisted hydrothermal synthesis and formation mechanism. J. Alloys Compd. 2011, 509, 885–890. [Google Scholar] [CrossRef]
- Zotti, G.; Schiavon, G.; Zecchin, S.; Casellato, U. Electrodeposition of Amorphous Fe2O3 Films by Reduction of Iron Perchlorate in Acetonitrile. J. Electrochem. Soc. 1998, 145, 385. [Google Scholar] [CrossRef]
- Beermann, N.; Vayssieres, L.; Lindquist, S.E.; Hagfeldt, A. (Photoelectrochemical studies of oriented nanorod thin films of hematite. J. Electrochem. Soc. 2000, 147, 2456. [Google Scholar] [CrossRef]
- Vayssieres, L.; Sathe, C.; Butorin, S.M.; Shuh, D.K.; Nordgren, J.; Guo, J. One-dimensional quantum-confinement effect in α-Fe2O3 ultrafine nanorod arrays. Advanc. Mater. 2005, 17, 2320–2323. [Google Scholar] [CrossRef]
- Goyal, R.N.; Pandey, A.K.; Kaur, D.; Kumar, A. Fabrication of α-Fe2O3 nanopowder modified glassy carbon electrode for applications in electrochemical sensing. J. Nanosci. Nanotechnol. 2009, 9, 4692–4699. [Google Scholar] [CrossRef]
- Sivakumar, S.; Anusuya, D.; Khatiwada, C.P.; Sivasubramanian, J.; Venkatesan, A.; Soundhirarajan, P. Characterizations of diverse mole of pure and Ni-doped α-Fe2O3 synthesized nanoparticles through chemical precipitation route. Spectrochim. Acta A Mol. Biomol. Spectrosc. 2014, 128, 69–75. [Google Scholar] [CrossRef] [PubMed]
- Patterson, A.L. The Scherrer formula for X-ray particle size determination. Phys. Rev. 1939, 56, 978. [Google Scholar] [CrossRef]
- Darezereshki, E. One-step synthesis of hematite (α-Fe2O3) nano-particles by direct thermal-decomposition of maghemite. Mater. Lett. 2011, 65, 642–645. [Google Scholar] [CrossRef]
- Pal, B.; Sharon, M. Preparation of iron oxide thin film by metal organic deposition from Fe (III)-acetylacetonate: A study of photocatalytic properties. Thin Solid Film. 2000, 379, 83–88. [Google Scholar] [CrossRef]
- Parhizkar, J.; Habibi, M.H. Synthesis, characterization and photocatalytic properties of Iron oxide nanoparticles synthesized by sol-gel autocombustion with ultrasonic irradiation. Nanochem. Res. 2017, 2, 166–171. [Google Scholar] [CrossRef]
- Jafarirad, S.; Hammami Torghabe, E.; Rasta, S.H.; Salehi, R. A novel non-invasive strategy for low-level laser-induced cancer therapy by using new Ag/ZnO and Nd/ZnO functionalized reduced graphene oxide nanocomposites. Artif. Cells Nanomed. Biotechnol. 2018, 46, 800–816. [Google Scholar] [CrossRef] [PubMed]
- Lee, B.; Lee, D.G. Synergistic antibacterial activity of gold nanoparticles caused by apoptosis-like death. J. Appl. Microbiol. 2019, 127, 701–712. [Google Scholar] [CrossRef]
- Wang, Y.; Chinnathambi, A.; Nasif, O.; Alharbi, S.A. Green synthesis and chemical characterization of a novel anti-human pancreatic cancer supplement by silver nanoparticles containing Zingiber officinale leaf aqueous extract. Arab. J. Chem. 2021, 14, 103081. [Google Scholar] [CrossRef]
- Bhushan, M.; Kumar, Y.; Periyasamy, L.; Viswanath, A.K. Antibacterial applications of α-Fe2O3/Co3O4 nanocomposites and study of their structural, optical, magnetic and cytotoxic characteristics. Appl. Nanosci. 2018, 8, 137–153. [Google Scholar] [CrossRef]
- Das, S.; Diyali, S.; Vinothini, G.; Perumalsamy, B.; Balakrishnan, G.; Ramasamy, T.; Biswas, B. Synthesis, morphological analysis, antibacterial activity of iron oxide nanoparticles and the cytotoxic effect on lung cancer cell line. Heliyon 2020, 6, 04953. [Google Scholar] [CrossRef] [PubMed]
- Henle, E.S.; Linn, S. Formation, prevention, and repair of DNA damage by iron/hydrogen peroxide. J. Biol. Chem. 1997, 272, 19095–19098. [Google Scholar] [CrossRef]
- Armijo, L.M.; Wawrzyniec, S.J.; Kopciuch, M.; Brandt, Y.I.; Rivera, A.C.; Withers, N.J.; Osiński, M. Antibacterial activity of iron oxide, iron nitride, and tobramycin conjugated nanoparticles against Pseudomonas aeruginosa biofilms. J. Nanobiotech. 2020, 18, 35. [Google Scholar] [CrossRef]
- Behera, S.S.; Patra, J.K.; Pramanik, K.; Panda, N.; Thatoi, H. Characterization and evaluation of antibacterial activities of chemically synthesized iron oxide nanoparticles. World J. Nano. Sci. Eng. 2012, 2, 196–200. [Google Scholar] [CrossRef]
- Hancock, J.T.; Desikan, R.; Neill, S.J. Role of reactive oxygen species in cell signalling pathways. Biochem. Soc. Trans. 2001, 29, 345–349. [Google Scholar] [CrossRef]
- Park, H.J.; Kim, J.Y.; Kim, J.; Lee, J.H.; Hahn, J.S.; Gu, M.B.; Yoon, J. Silver-ion-mediated reactive oxygen species generation affecting bactericidal activity. Water Res. 2009, 43, 1027–1032. [Google Scholar] [CrossRef] [PubMed]
- Keenan, C.R.; Sedlak, D.L. Factors affecting the yield of oxidants from the reaction of nanoparticulate zero-valent iron and oxygen. Environ. Sci. Technol. 2008, 42, 1262–1267. [Google Scholar] [CrossRef] [PubMed]
- Vasantharaj, S.; Sathiyavimal, S.; Senthilkumar, P.; LewisOscar, F.; Pugazhendhi, A. Biosynthesis of iron oxide nanoparticles using leaf extract of Ruellia tuberosa: Antimicrobial properties and their applications in photocatalytic degradation. J. Photochem. Photobiol. B Biol. 2019, 192, 74–82. [Google Scholar] [CrossRef] [PubMed]
- Singh, M.P.; Rai, S.N.; Dubey, S.K.; Pandey, A.T.; Tabassum, N.; Chaturvedi, V.K.; Singh, N.B. Biomolecules of mushroom: A recipe of human wellness. Crit. Rev. Biotechnol. 2022, 42, 913–930. [Google Scholar] [CrossRef]
- Kim, J.S.; Kuk, E.; Yu, K.N.; Kim, J.H.; Park, S.J.; Lee, H.J.; Cho, M.H. Antimicrobial effects of silver nanoparticles. Nanomed. Nanotechnol. Biol. Med. 2007, 3, 95–101. [Google Scholar] [CrossRef] [PubMed]
- Tabassum, N.; Kumar, D.; Verma, D.; Bohara, R.A.; Singh, M.P. Zirconium oxide (ZrO2) nanoparticles from antibacterial activity to cytotoxicity: A next-generation of multifunctional nanoparticles. Mater. Today Commun. 2021, 26, 102156. [Google Scholar] [CrossRef]
- Bhakya, S.; Muthukrishnan, S.; Sukumaran, M.; Muthukumar, M. Biogenic synthesis of silver nanoparticles and their antioxidant and antibacterial activity. Appl. Nanosci. 2016, 6, 755–766. [Google Scholar] [CrossRef]
- Contreras-Guzmán, E.S.; Strong, F.C. Determination of tocopherols (vitamin E) by reduction of cupric ion. J. Assoc. Off. Anal. Chem. 1982, 65, 1215–1221. [Google Scholar] [CrossRef]
- Catana, R.; Helepciuc, F.E.; Zamfir, M.; Florescu, L.; Mitoi, M. In vivo and in vitro antioxidant activity of Cnicus benedictus. AgroLife Sci. J. 2020, 9, 73–78. [Google Scholar]

| Concentration (µg/mL) | * Zone of Inhibition (mm) Mean ± SD | ||
|---|---|---|---|
| S. aureus | K. pneumoniae | E. coli | |
| Control | 5 | 5 | 5 |
| 10 | 8.3 ± 0.4 | 8.4 ± 0.4 | 10.4 ± 0.5 |
| 20 | 10.2 ± 0.2 | 10.1 ± 0.1 | 14.1 ± 0.1 |
| 30 | 14.4 ± 0.3 | 13.4 ± 0.4 | 16.3 ± 0.3 |
| 40 | 16.2 ± 0.2 | 17.2 ± 0.2 | 19.3 ± 0.3 |
Disclaimer/Publisher’s Note: The statements, opinions and data contained in all publications are solely those of the individual author(s) and contributor(s) and not of MDPI and/or the editor(s). MDPI and/or the editor(s) disclaim responsibility for any injury to people or property resulting from any ideas, methods, instructions or products referred to in the content. |
© 2023 by the authors. Licensee MDPI, Basel, Switzerland. This article is an open access article distributed under the terms and conditions of the Creative Commons Attribution (CC BY) license (https://creativecommons.org/licenses/by/4.0/).
Share and Cite
Tabassum, N.; Singh, V.; Chaturvedi, V.K.; Vamanu, E.; Singh, M.P. A Facile Synthesis of Flower-like Iron Oxide Nanoparticles and Its Efficacy Measurements for Antibacterial, Cytotoxicity and Antioxidant Activity. Pharmaceutics 2023, 15, 1726. https://doi.org/10.3390/pharmaceutics15061726
Tabassum N, Singh V, Chaturvedi VK, Vamanu E, Singh MP. A Facile Synthesis of Flower-like Iron Oxide Nanoparticles and Its Efficacy Measurements for Antibacterial, Cytotoxicity and Antioxidant Activity. Pharmaceutics. 2023; 15(6):1726. https://doi.org/10.3390/pharmaceutics15061726
Chicago/Turabian StyleTabassum, Nazish, Virendra Singh, Vivek K. Chaturvedi, Emanuel Vamanu, and Mohan P. Singh. 2023. "A Facile Synthesis of Flower-like Iron Oxide Nanoparticles and Its Efficacy Measurements for Antibacterial, Cytotoxicity and Antioxidant Activity" Pharmaceutics 15, no. 6: 1726. https://doi.org/10.3390/pharmaceutics15061726
APA StyleTabassum, N., Singh, V., Chaturvedi, V. K., Vamanu, E., & Singh, M. P. (2023). A Facile Synthesis of Flower-like Iron Oxide Nanoparticles and Its Efficacy Measurements for Antibacterial, Cytotoxicity and Antioxidant Activity. Pharmaceutics, 15(6), 1726. https://doi.org/10.3390/pharmaceutics15061726

